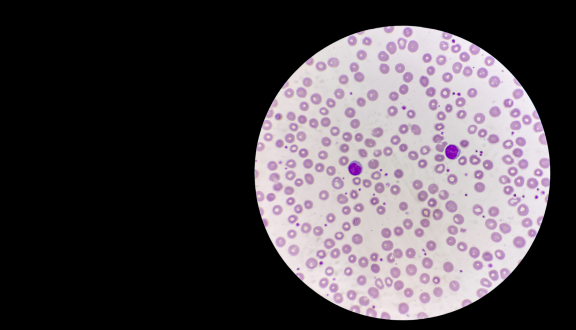

Gilberto Corbellini

Gilberto Corbellini insegna storia della medicina e bioetica alla Sapienza Università di Roma ed è direttore del Museo di storia della medicina - Dipartimento di medicina molecolare. Scrive sull'inserto culturale Domenica de Il Sole 24 Ore e ha pubblicato diversi libri, tra cui: Perché gli scienziati non sono pericolosi (Longanesi, 2009), Scienza, quindi democrazia (Einaudi 2011), Scienza (Bollati Boringhieri 2013); Nel Paese della Pseudoscienza. Perché i pregiudizi minacciano la nostra libertà. Milano, Feltrinelli, 2019. Vedi bio completa su Wikipedia.
di Gilberto Corbellini
7 Jan 2026
di Gilberto Corbellini
16 Dec 2025
di Gilberto Corbellini
19 Nov 2025
di Gilberto Corbellini
10 Nov 2025
di Gilberto Corbellini
22 Jul 2025
di Gilberto Corbellini
18 Jun 2025
di Gilberto Corbellini
30 Apr 2020
di Enrico Bucci, Gilberto Corbellini, Michele De Luca
28 Mar 2020
di Gilberto Corbellini
15 Dec 2019